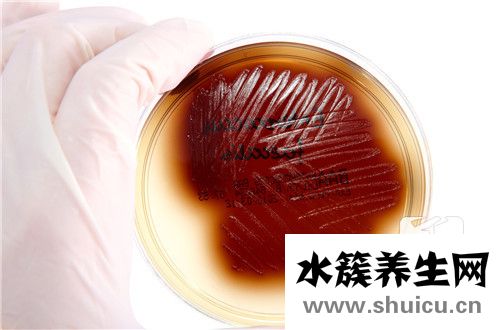
氣郁

許多女性有氣滯血瘀一些研究表明,大多數氣滯血瘀的女性都是內向的人。這些人平時容易產生抑郁情緒,尤其是遇到不愉快的事情時,往往無法很好地控制自己的不良情緒,導致肝氣郁結,月經不調、血塊等氣滯血瘀癥狀緩慢發(fā)作。

一、氣郁血瘀的概念
“氣郁”體質指的是體內心情不暢,氣機郁結所導致的一系列癥狀,表現為心情壓抑、焦慮憂愁、經常嘆息、胸脅脹悶、月經不調等癥狀。“血瘀”體質指的是體內血液運行不暢或者淤血所表現出來的一系列癥狀;表現為身體疼痛、面色黧黑、口唇發(fā)青、女性月經不調或痛經等癥狀。臨床上,“氣郁”與“血瘀”會互相影響;可由原先氣機運行不暢,導致血液凝滯;又或者血液凝滯導致氣機不暢;常共同存在,稱為“氣滯血瘀”。
二、氣郁血瘀的調理方法
1、調暢情緒
肝有調達氣機、輔助行氣活血的功效;因此,保持心情愉快,少生悶氣,碰到困難要及時去解決,可以改變“氣郁”的狀態(tài),進而調達氣血,這是養(yǎng)生的基礎。
2、加強運動
如果經常久坐久站,缺乏運動,血液就會凝滯,身體多會出現疲勞疼痛的現象;所以日常要加強運動,使得氣血流暢。
3、避風寒
居住溫暖。寒則血凝,血脈受寒,就血瘀不通,就像水管結冰一樣;因此居住地要溫暖向陽,日常少吹冷氣,注意防寒保暖。
4、注意飲食
多吃有行氣、活血功能的食品,如:大蒜、生姜、茴香、洋蔥、桂皮、柑橘、山楂等。
戒煙限酒
過分的吸煙,酗酒,一氧化碳會與體內的血紅蛋白結合減慢血液循環(huán),尤其是血瘀體質,它會使體內累積更多的痰濁,從而形成瘀血。
保證睡眠
成年人平均每個晚上需要7-8個小時的高質量睡眠,才能夠保證人體健康。但是很多血瘀體質者常常由于工作的壓力導致睡眠不足,免疫系統失調。
泡腳
每天用熱水泡浴,有利于改善全身氣血運行,如能定期進行藥浴、按摩,則效果更好。

三、氣滯血瘀的飲食宜忌
喜食油膩厚味、甜食,或攝入過多鹽分、飲水不足都會導致血液過分粘稠,最終導致氣血運行不暢,引發(fā)血瘀。氣滯血瘀體質宜少吃鹽和味精,不宜吃甘薯、芋艿、等容易脹氣的食物;不宜多吃肥肉、奶油、蟹黃、蛋黃、魚籽、油炸食品、冷飲,防止血脂增高,阻塞血管,影響氣血運行。
常識告訴我們,人類生活中的許多疾病都可以自然治愈。例如,扁桃體角化病是一種疾病,可以通過良好的生活習慣和科學的飲食來調整,以盡量減少疾病對患者的影響。那么扁桃體角化病真的能自行痊愈嗎?所以如...
青春期是一個非常重要的時期。兒童的身體和心理已經開始發(fā)生變化,他們也是叛逆的。青春期是學校教育的關鍵階段。無論是初中還是高中,對普通家庭來說都有著重要的意義。如果你想到未來的大學,沒有好...
大腿背部疼痛的癥狀有多種原因,如腰椎間盤突出、腰椎異常、坐姿不良、神經受壓、劇烈運動后過度勞累等。那么,什么是造成大腿背部疼痛的原因,有什么具體的好方法或小技巧可以用來緩解和改善治療?現在...
目前,許多人更喜歡洗面奶,因為經過一天的風吹日曬,皮膚必須用洗面奶徹底清潔,否則會留下很多損傷,可能會有粉刺和毛孔堵塞,洗面奶氨基酸更有效,但也不能隨便使用,如果皮膚更敏感,可以自己做洗面奶...
在生活中,每個人都非常重視自己的面部皮膚。只有好的皮膚才能保證他們的形象和氣質。然而,有許多方法來護理面部皮膚。例如,有些人喜歡將生理鹽水涂在臉上,這樣可以清潔皮膚,有效去除面部油脂,從而預防...
我感覺有東西在我的腦海里移動。造成這種情況的原因有很多,如神經衰弱、情緒不穩(wěn)定、幻覺、幻覺、抑郁、自主神經功能障礙、腦缺血、高血壓等。具體原因是什么?應該如何提供有效的救濟?下面讓我們逐...
因為成分不同,玉髓有很多種顏色,如著名的紅色玉髓、白色玉髓、黃色玉髓等等,還有藍色玉髓。藍色玉髓實際上是瑪瑙家族的一員。這種藍色非常漂亮。生活中有些人特別喜歡藍色,尤其喜歡藍色玉髓。藍色玉...
粉眉又被稱為細胞內微妙顏色的插入,就像淡淡的感覺,淡淡的,薄薄的,就像眉毛掃粉時的霧。它不會變紅、變藍或變暗,給人一種清新、自然、優(yōu)雅和大方的感覺。霧眉之所以簡稱霧眉,是因為它的效果就像眉粉掃...
在生活中,每個人都知道紅細胞含有血紅蛋白,而血紅蛋白含有微量元素鐵。因此,如果血紅蛋白低,就會引起缺鐵性貧血。如果人體內的紅細胞數量減少,就會導致貧血。如果紅細胞數量急劇下降,就有可能威脅到人...
瑪瑙和玉髓眾所周知。事實上,兩者的本質都是礦物質。事實上,玉髓中含有多種礦物質。瑪瑙是其中之一?,旇罪椃浅0嘿F,但也吸引了許多消費者。無論是瑪瑙還是玉髓,都有許多顏色。然而,在未來,我們應該...
硒是人體的生命之火,是人體內不可缺少的營養(yǎng)成分,生活中很多水果都含有硒元素,但你知道含硒第一名的水果是什么嗎?含硒高的水果又有哪些呢?跟水簇養(yǎng)生網一起來看看吧。...
一級夫妻性生活的年紀大概在20歲到50歲左右,如果是一種比較好的情況下,性生活的頻率一般在10到20分鐘左右,如果是比較差的夫妻,性生活的頻率可能會受到很多因素的影響,有些人可能會擔心,性生活的質量不...
黃ba等中草藥可用于治療多種男科疾病。 可是不應過多使用。 畢竟,該藥具有三點毒性,并且肯定會引起身體某些副作用,尤其是對腎功能的影響,將產生非常大的影響,因此一定應該引起注意, 可能會繼續(xù)導致自...
三道鱗魚是歐美鯽魚的一種變異魚,它在人體表面的鱗片很大。所以在歐洲的一些地區(qū),經常有人用三道鱗魚來曬蝦米作為鏡子,所以三道鱗魚也有另外一個名字,鏡魚。如今,三道鱗魚已經被引入中國許多地區(qū)進行...
在我們的日常生活中,桂花酒屬于一種常見的酒,具有桂花樹的香味和多種營養(yǎng)元素,特別適合冬季飲用。桂花酒可以暖身祛寒作用,還可以合理減少疲勞功效,改善睡眠質量等。...
許多人喜歡在冬天去釣魚。在這種情況下,米酒通常被用作巢的材料。對于一些更有經驗的人來說,筑巢是非常好的。然而,許多人沒有做好并死去。死亡巢穴的出現有很多原因??赡苁侵谱鞒擦蠒r香料的味道太...
三角肌 注射是預防接種醫(yī)院門診的重點工作。精確定位和選擇合適的位置對于確保安全注射非常重要。三角肌注射/的正確方式是什么?三角肌宜注射方法是將右手收緊在部分皮膚上,將無名指固定在針上,使針...
我堅信很多人都吃過馬鮫魚,這是一種有價值的魚,營養(yǎng)含量很高,比如蛋白質豐富多彩。另外,馬鮫魚含有維生素A和各種礦物質元素。據了解,食用馬鮫魚具有補氣養(yǎng)血的功效,還具有止咳化痰的功效。女性可以通...
夏天很多人喜歡買泥鰍吃。泥鰍有很多做法,比如蒸、炸等等。它是一種人們非常喜歡吃的食物。而且泥鰍的營養(yǎng)價值也很高,但是每次吃的時候處理掉泥鰍是個麻煩的問題,尤其是如果內臟需要清理的話。所以...
相信很多人都用過上海藥皂,它是中國上海第一塊特效除菌皂,那么上海藥皂都有什么作用呢?下面就來說說上海藥皂的功效與作用,一起來了解下吧。...